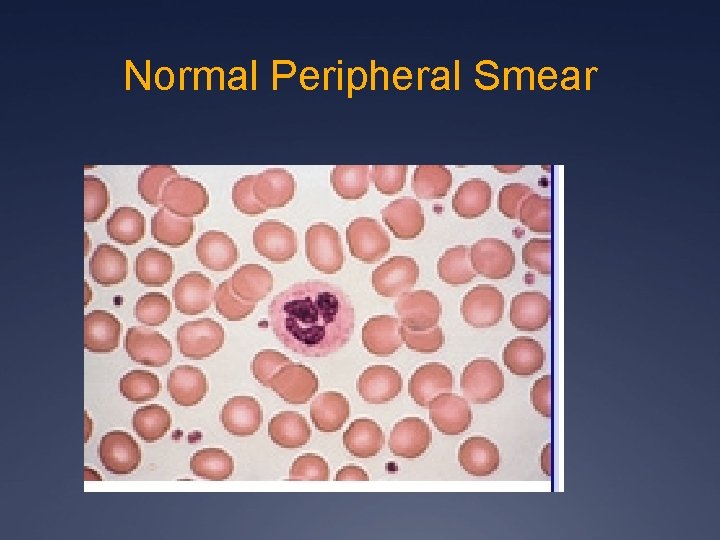
Normal Peripheral Smear

ANEMIA Iron deficiency Objectives Learn about iron deficiency

ANEMIA Iron deficiency

Objectives Ü Learn about iron deficiency anemia Ü Learn about anemic of chronic disease Ü Distinguish between iron deficiency anemia and anemia of chronic disease

What is Anemia? Ü Anemia is defined by reduction in Hg Concentration, Hct Concentration or RBC count Ü Or defined as 2 standard deviations below the mean Ü WHO criteria is Hg < 13 in men and Hg < 12 in women Ü Revised WHO criteria : Hg < 14 in men and Hg < 12

Symptoms Ü Exertional dyspnea and Dyspnea at Exertion Ü Headaches Ü Fatigue Ü Bounding pulses and Roaring in the Ears Ü Palpitations Ü PICA

Physical Manifestation : “Spoon Nails” in Iron Deficiency

Kinetic Approach Ü Decreased RBC production Ü Lack of nutrients (B 12, folate, iron) Ü Bone Marrow Disorder Ü Bone Marrow Suppression Ü Increased RBC destruction Ü Inherited and Acquired Hemolytic Anemias Ü Blood Loss

Morphological Approach Ü Microcytic (MCV < 80) Ü Reduced iron availability Ü Reduced heme synthesis Ü Reduced globin production Ü Normocytic ( 80 < MCV < 100) Ü Macrocytic (MCV > 100) Ü Liver disease, B 12, folate

Labs Ü Information can be gleaned from good history taking and a physical exam (pallor, jaundice, etc) Ü CBC With Diff Ü Leukopenia with anemia may suggest aplastic anemia Ü Increased Neutrophils may suggest infection Ü Increased Monocytes may suggest Myelodysplasia Ü Thrombocytopenia may suggest hypersplenism, marrow involvement with malignancy, autoimmune destruction, folate deficiency Ü Reticulocyte Count Ü Peripheral Smear

Iron Deficiency Anemia Ü Low Retic Count Ü High RDW Ü Low iron level Ü High TIBC Ü Low ferritin

Degrees of Iron Deficiency
Normal Peripheral Smear

Iron Deficiency Anemia: Peripheral Smear Microcytosis &, Hypochromic RBCs

Reticulocyte Count Ü Reticulocyte count is the percent of immature RBCs (released earlier in anemia from the marrow) Ü Normal levels 0. 5 -1. 5% for non anemic stages Ü <1% means Inadequate Production Ü >/equal to 1 means increased production (hemolysis) Ü Corrected reticulocyte count compares anemic to non-anemic counterparts to assess response as reticulocyte count may overestimate response Ü Corrected Reticulocyte Count = % Retic X HCT/45

Reticulocytes

Reticulocyte Correction Factor Ü RPI = % reticulocytes X HCT/45 X 1/Correction Factor Hematocrit Correction Factor 40 -45 1 35 -39 1. 5 25 -34 2 15 -24 2. 5 Ü Normal RPI =1 Ü RPI < 2 Hypoproliferative Ü RPI greater than/equal 2 Hyperproliferative Disorder

So now that it’s iron deficiency…. Ü What Causes Iron Deficiency? Ü Blood Loss (occult or overt): PUD, Diverticulosis, Colon Ü Ü Cancer Decreased Iron Absorption: achlorhydria, atrophic gastritis, celiac disease Foods and Medications: phytate, calcium, soy protein, polyphenols decrease iron absorption Uncommon causes: intravascular hemolysis, pulmonary hemosiderosis, EPO, gastric bypass Decreased Intake (rare)


Who needs a GI work-up? Ü All men, all women without menorrhagia, women greater than 50 with menorrhagia Ü If UGI symptoms, EGD Ü If asymptomatic, colonoscopy Ü Women less than 50 plus menorrhagia: consider GI workup based upon symptoms


Gold Standard for Diagnosis Ü Bone Marrow Biopsy Ü Prussian Blue staining shows lack of iron in erythroid precursors and macrophages Ü However, it is invasive and costly

Treatment Options

Anemia of Chronic Disease Ü EPO production inadequate for the degree of anemia observed or erythroid marrow responds inadequately to stimulation Ü Causes: inflammation, infection, tissue injury, cancer Ü Low serum iron, increased red cell porphyrin, transferrin 15 -20%, normal to increased ferritin

Pathophysiology

AICD vs. Iron Deficiency Ü Soluble Transferrin Receptor: elevated in cases of iron deficiency Ü Ferritin: elevated in anemia of chronic disease Ü If all else fails, Bone Marrow Biopsy Ü In anemia of chronic disease: macrophages contain normal/ increased iron & erythroid precursors show decreased/absent amounts of iron

Anemia of Chronic Disease

Treatment Ü Treat the underlying cause Ü And Treat the Underlying Cause! Ü Consider co-existent iron deficiency as well Ü If underlying disease state requires it, consider EPO injection

Summary

References Ü Harrison’s Principles of Internal Medicine Ü Adamson JW. Chapter 103. Iron Deficiency and Other Hypoproliferative Anemias. In: Longo DL, Fauci AS, Kasper DL, Hauser SL, Jameson JL, Loscalzo J, eds. Harrison's Principles of Internal Medicine. 18 th ed. New York: Mc. Graw-Hill; 2012. http: //www. accessmedicine. com/content. aspx? a. ID=9117223. Accessed December 7, 2011 Ü Wians, F. H. and Urban JE. “Discriminating between Anemia of Chronic disease Using Traditional Indices of Iron Status v. Transferring Receptor Concentration”. 2001. American Journal of Clinical Pathology. Volume 115. Ü Upto. Date Ü Ü Schrier, SL. Approach to the adult patient with anemia. In: Up. To. Date, Landaw, SA(ED). Upto. Date, Waltham, MA. 2012. Schrier, SL. Causes and diagnosis of anemia due to iron deficiency. In: Up. To. Date. Landaw, SA. (ED). Uptodate, Waltham, MA. 2012.
- Slides: 28